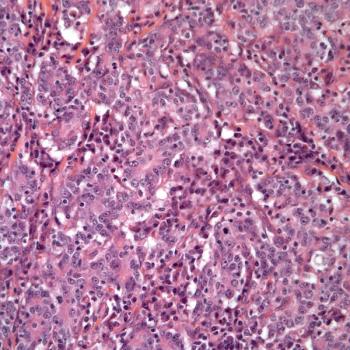
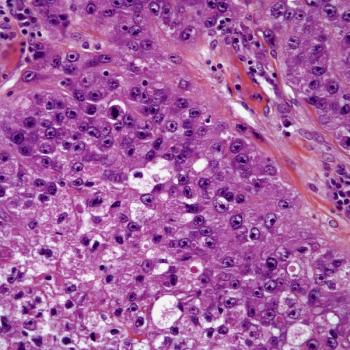

A 38-year-old man presents with a lesion in the tibia, and a biopsy is performed. What is your diagnosis?

Your AI-Trained Oncology Knowledge Connection!


A 38-year-old man presents with a lesion in the tibia, and a biopsy is performed. What is your diagnosis?

A 49-year-old woman presents with a brain lesion, and a biopsy is performed. What is your diagnosis?

A 46-year-old man presents with hematuria, and a bladder biopsy is performed. What is your diagnosis?

A 32-year-old woman presents with vaginal bleeding, and a cervical biopsy is obtained. What is your diagnosis?

A 43-year-old man presents with a mass lesion in the pelvis, and a biopsy is performed. What is your diagnosis?

A 42-year-old woman presents with a parotid gland tumor, and a biopsy is performed. What is your diagnosis?

A 31-year-old man presents with a peritoneal mass, and a biopsy is performed. What is your diagnosis?
A 67-year-old man presents with gastric pain, and a biopsy is performed. What is your diagnosis?

A 47-year-old man presents with a liver mass, and a biopsy is performed. What is your diagnosis?

A 52-year-old man presents with a lesion on his eyelid, and a biopsy is performed. What is your diagnosis?

A 48-year-old man presents with a lesion on his forearm, and a biopsy is performed. What is your diagnosis?

A 2-year-old child is found to have a pineal mass, and a biopsy is performed. What is your diagnosis?

A lesion is found in the right breast of a 40-year-old woman, and a biopsy is performed. What is your diagnosis?

An 18-year-old man presents with a tumor in his humerus, and a biopsy is performed. What is your diagnosis?

A 32-year-old man presents with persistent diarrhea, and a colon biopsy is obtained. What is your diagnosis?

A 34-year-old woman presents with a lesion on the right side of her neck, and a biopsy is performed. What is your diagnosis?

A 27-year-old man presents with a lesion in the right scapular region, and a biopsy is performed. What is your diagnosis?

A 54-year-old man presents with abdominal pain, and a colon biopsy is obtained. What is your diagnosis?

A 43-year-old man presents with an anterior mediastinal mass. The mass is surgically resected and a biopsy is performed. What is your diagnosis?

A 19-year-old man is found to have a lesion in his nasopharynx, and a biopsy is performed. What is your diagnosis?

A 54-year-old man presents with dyspnea and chest pain. An intrapulmonary mass is found. What is your diagnosis?

A 54-year-old woman is found to have a skin lesion on her right arm, and a biopsy is performed. What is your diagnosis?

A 5-month-old boy is found to have a kidney tumor, and a biopsy is performed. What is your diagnosis?

A 42-year-old woman presents with a breast mass, and a biopsy is performed. What is your diagnosis?

A 43-year-old woman presents with vaginal bleeding, and an endocervical biopsy is performed. What is you diagnosis?

A 60-year-old man with a history of chronic obstructive pulmonary disease presents with pain in the left side of his abdomen. What is your diagnosis?

A 47-year-old woman presents with a mass in her right calf, and a biopsy is performed. What is your diagnosis?

A 32-year-old man presents with a mass on his left thigh, and a biopsy is performed. What is your diagnosis?

A 48-year-old man presents with diffuse pulmonary infiltrates, and a biopsy is performed. What is your diagnosis?
A 38-year-old man presents with a right shoulder mass, and a biopsy is performed. What is your diagnosis?